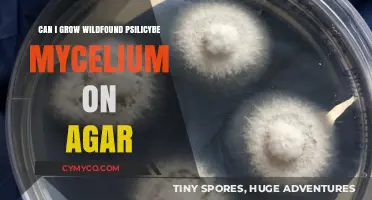
Exploring the Cultivation of Wild Psilocybe Mycelium on Agar

Pairing Mycelium with Exodus Wallet: A Comprehensive Guide
In the realm of cryptocurrency, the Mycelium wallet stands out as a popular choice for Android users due to its robust security features and user-friendly interface. On the other hand, the Exodus wallet is renowned for its sleek design and multi-currency support, making it a favorite among both beginners and experienced crypto enthusiasts. The question of whether these two wallets can be paired is a common one, and the answer is yes, but with certain considerations. This guide will walk you through the process of pairing your Mycelium wallet with Exodus, highlighting the benefits and potential challenges you may encounter along the way.
Explore related products
What You'll Learn
- Compatibility: Check if Mycelium and Exodus wallets are compatible for pairing on your device
- Security: Understand the security implications of pairing Mycelium with Exodus, including potential risks
- Steps: Follow the step-by-step process to successfully pair Mycelium with Exodus wallet
- Benefits: Explore the advantages of integrating Mycelium with Exodus for enhanced cryptocurrency management
- Troubleshooting: Learn how to address common issues that may arise when pairing Mycelium to Exodus

Compatibility: Check if Mycelium and Exodus wallets are compatible for pairing on your device
To determine if Mycelium and Exodus wallets are compatible for pairing on your device, you need to consider several factors. First, check the operating system requirements for both wallets. Mycelium is primarily designed for Android devices, while Exodus supports both Android and iOS. If you're using an iPhone, Exodus would be the more suitable choice. Next, verify the compatibility of the wallet versions. Older versions of Mycelium may not pair seamlessly with the latest version of Exodus, so ensure you have the most recent updates installed.
Another crucial aspect to consider is the type of connection you're using. Mycelium and Exodus both support Bluetooth pairing, but the efficiency of the connection can vary depending on the device's Bluetooth capabilities. For optimal performance, ensure that your device has Bluetooth 4.0 or higher. Additionally, check for any known issues or bugs related to pairing these specific wallets. Online forums and the wallets' official websites often provide troubleshooting guides and user feedback that can help identify potential problems.
Once you've confirmed the basic compatibility, the next step is to test the pairing process. Open both wallets on your device and initiate the pairing sequence. Follow the on-screen instructions carefully, as the process may involve scanning QR codes or entering specific codes. If the pairing is successful, you should see a confirmation message on both wallets.
It's also important to consider the security implications of pairing these wallets. Ensure that you're using a secure connection and that both wallets have strong security features enabled, such as two-factor authentication and encryption. Avoid pairing wallets on public Wi-Fi networks or devices that you don't trust.
In conclusion, while Mycelium and Exodus wallets can be paired on compatible devices, it's essential to verify the operating system requirements, wallet versions, and connection capabilities before initiating the pairing process. By following these steps and considering the security implications, you can ensure a smooth and secure pairing experience.
Breaking Up Mycelium Cakes: A Guide to Proper Cultivation Techniques
You may want to see also
Explore related products

Security: Understand the security implications of pairing Mycelium with Exodus, including potential risks
Pairing Mycelium with Exodus can have several security implications that users need to be aware of. One potential risk is the increased attack surface that comes with integrating two separate wallets. If one wallet is compromised, it could potentially lead to the other wallet being vulnerable as well. Additionally, users need to ensure that they are using the correct and official versions of both wallets to avoid any phishing or malware attacks.
Another security consideration is the transfer of funds between the two wallets. Users should be cautious when transferring large amounts of cryptocurrency and ensure that they are sending funds to the correct address. It's also important to note that once funds are transferred, they cannot be easily reversed, so users need to double-check all transactions before confirming them.
Furthermore, users should be aware of the different security features offered by each wallet. Mycelium, for example, offers a cold storage option that can provide an additional layer of security for users who want to store their funds offline. Exodus, on the other hand, offers a built-in exchange feature that allows users to trade cryptocurrencies directly within the wallet. Users should carefully evaluate the security features of each wallet and decide which ones best meet their needs.
In conclusion, while pairing Mycelium with Exodus can offer some benefits, such as increased functionality and convenience, it's important for users to carefully consider the potential security risks involved. By taking the necessary precautions and understanding the security implications of integrating two separate wallets, users can minimize the risks and enjoy the benefits of using both wallets together.
Do Mobs Spawn on Mycelium? Exploring Minecraft's Fungal Terrain
You may want to see also
Explore related products

Steps: Follow the step-by-step process to successfully pair Mycelium with Exodus wallet
To successfully pair Mycelium with Exodus wallet, follow these detailed steps:
- Ensure Compatibility: First, verify that both Mycelium and Exodus wallets are installed on the same device. This process is crucial as it ensures seamless communication between the two applications.
- Open Mycelium Wallet: Launch the Mycelium app on your device. Navigate to the settings menu, usually represented by three horizontal lines or a gear icon, depending on the app's version.
- Select 'Pair with Exodus' Option: Within the settings menu, look for an option labeled 'Pair with Exodus' or similar. This option is specifically designed to facilitate the pairing process between Mycelium and Exodus wallets.
- Initiate Pairing: Tap on the 'Pair with Exodus' option. You might be prompted to confirm your action or enter a pairing code. Follow the on-screen instructions carefully to proceed.
- Open Exodus Wallet: Switch to the Exodus app. Ensure that you are on the correct network (e.g., Bitcoin or Ethereum) that you intend to use with Mycelium.
- Complete Pairing in Exodus: In the Exodus app, navigate to the settings or options menu. Look for a prompt or option to complete the pairing process initiated in Mycelium. This might involve scanning a QR code or entering a pairing key.
- Verify Connection: Once the pairing is complete, verify the connection by attempting to send or receive funds between the two wallets. This step confirms that the pairing was successful and that both wallets are communicating effectively.
By following these steps, you can ensure a smooth and successful pairing of Mycelium with Exodus wallet, enabling you to leverage the features of both applications seamlessly.
Unlocking Potency: The Impact of Long-Grown Mycelium on Shrooms
You may want to see also
Explore related products

Benefits: Explore the advantages of integrating Mycelium with Exodus for enhanced cryptocurrency management
Integrating Mycelium with Exodus offers several benefits for enhanced cryptocurrency management. One of the primary advantages is the ability to leverage Mycelium's robust security features, such as its hierarchical deterministic (HD) wallet architecture, which allows for the generation of multiple addresses from a single seed. This integration can provide Exodus users with an additional layer of security and flexibility in managing their cryptocurrency assets.
Another benefit of pairing Mycelium with Exodus is the potential for improved transaction efficiency. Mycelium's advanced fee estimation algorithms can help Exodus users optimize their transaction fees, ensuring that they are neither overpaying nor underpaying for their transactions. This can be particularly useful in times of high network congestion, where accurate fee estimation is crucial for timely transaction processing.
Furthermore, the integration of Mycelium with Exodus can offer users a more comprehensive set of tools for managing their cryptocurrency portfolios. Mycelium's support for various cryptocurrencies, including Bitcoin, Ethereum, and others, can complement Exodus's existing multi-currency support, providing users with a more diverse range of options for their cryptocurrency investments.
Additionally, the combination of Mycelium's user-friendly interface with Exodus's intuitive design can create a seamless user experience for cryptocurrency enthusiasts. This integration can make it easier for users to navigate between different wallets, track their transaction history, and monitor their portfolio performance, all within a single, unified platform.
In conclusion, the integration of Mycelium with Exodus can offer significant advantages for cryptocurrency users, including enhanced security, improved transaction efficiency, a more comprehensive set of portfolio management tools, and a seamless user experience. By combining the strengths of both platforms, users can enjoy a more robust and versatile cryptocurrency management solution.
Unveiling the Mysteries of Mycelium: A Deep Dive into Nature's Network
You may want to see also
Explore related products

Troubleshooting: Learn how to address common issues that may arise when pairing Mycelium to Exodus
Pairing Mycelium with Exodus can sometimes encounter issues, but with the right troubleshooting steps, these can be resolved efficiently. One common problem is the failure to establish a connection between the two wallets. This could be due to several reasons such as outdated software, incorrect pairing codes, or network connectivity issues. To address this, ensure both wallets are updated to the latest version and check your internet connection. Restarting the pairing process and double-checking the pairing codes can also help resolve connection failures.
Another issue users might face is the inability to transfer funds between the paired wallets. This could be due to insufficient balance, incorrect address input, or transaction fee issues. To troubleshoot this, verify that you have enough funds in the sending wallet and that the receiving address is correct. Adjusting the transaction fee to a higher value can also expedite the transfer process.
Security concerns are paramount when dealing with cryptocurrency wallets. If you suspect unauthorized access or phishing attempts, it's crucial to take immediate action. Change your passwords, enable two-factor authentication if not already done, and contact the wallet's support team for further assistance. Regularly backing up your wallet data can also prevent data loss in case of security breaches.
Performance issues such as slow transaction processing or app crashes can be frustrating. These can often be resolved by clearing the app cache, restarting the device, or reinstalling the wallet apps. If the problem persists, check for any known issues or updates from the wallet developers.
Lastly, it's important to be aware of the limitations and compatibility issues between different wallet versions or operating systems. Always refer to the official documentation or support resources provided by Mycelium and Exodus for the most accurate and up-to-date information. By following these troubleshooting steps, you can effectively address common issues and ensure a smooth pairing experience between Mycelium and Exodus wallets.
Exploring Mycelium Bitcoin Wallets: Accessibility and Usage Insights
You may want to see also
Frequently asked questions
Yes, you can pair Mycelium to Exodus wallet. Both wallets support the same cryptocurrencies and have similar functionalities.
To pair Mycelium to Exodus wallet, you need to have both wallets installed on your device. Then, you can use the pairing feature in either wallet to connect them.
Pairing Mycelium to Exodus wallet allows you to easily transfer funds between the two wallets, use the same seed phrase for both wallets, and have a backup of your funds in case one wallet is lost or damaged.
There are no significant risks associated with pairing Mycelium to Exodus wallet. However, it is important to note that if one wallet is compromised, the other wallet may also be at risk.
Yes, you can unpair Mycelium from Exodus wallet at any time. This will disconnect the two wallets and you will no longer be able to transfer funds between them.


























![Exodus: Gods and Kings [Blu-ray]](https://m.media-amazon.com/images/I/81lRyOkixvL._AC_UL320_.jpg)










![Exodus (1960) [ Blu-Ray, Reg.A/B/C Import - Spain ]](https://m.media-amazon.com/images/I/71k2ElaF-ZL._AC_UL320_.jpg)